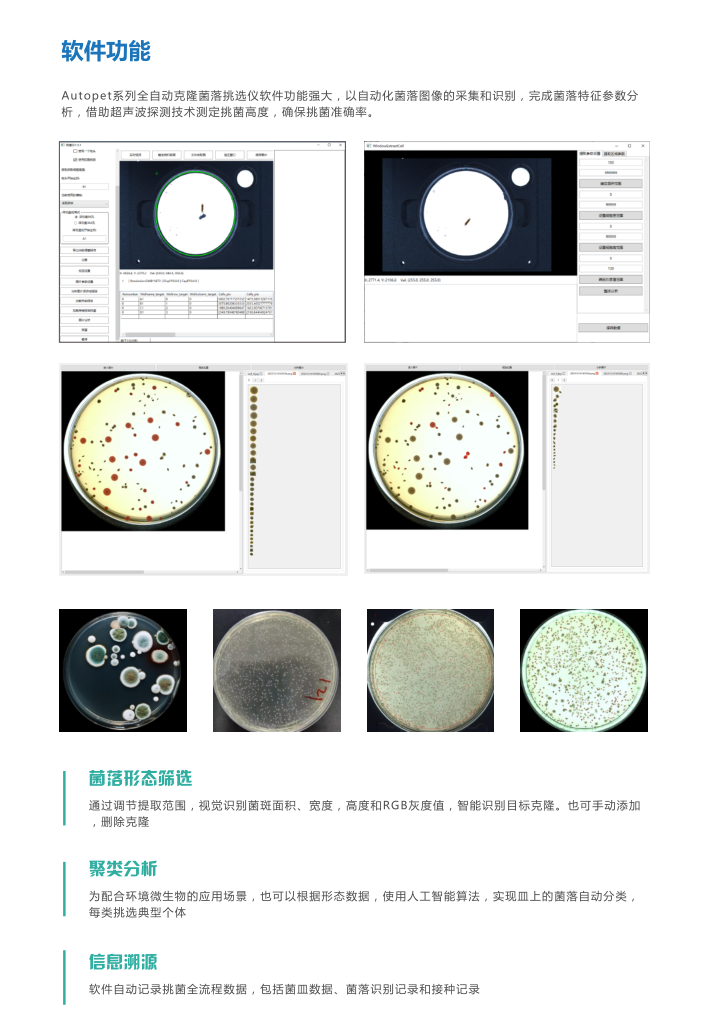
产品细节图片6

万千商家帮你免费找货
0 人在求购买到急需产品
- 详细信息
- 文献和实验
- 技术资料
- 库存:
大量
- 保修期:
一年
- 现货状态:
现货
- 供应商:
佛山市德淙科学仪器有限公司
挑选工具。设备运行中菌皿自动开盖、成像、挑菌互不影响,挑菌完成后,菌皿自动关盖、挑菌针
清洁消杀互不影响。挑菌速度每小时最快可达2400个单克隆菌落

风险提示:丁香通仅作为第三方平台,为商家信息发布提供平台空间。用户咨询产品时请注意保护个人信息及财产安全,合理判断,谨慎选购商品,商家和用户对交易行为负责。对于医疗器械类产品,请先查证核实企业经营资质和医疗器械产品注册证情况。
文献和实验【公告】丁香通试用中心:10月免费试用装精选(10月18日有更新)
blot显色液 HIV-1P24抗原检测试剂盒 Carrier RNA 免费试用装 兔抗人胱抑素C多克隆抗体 DMEM培养基(高糖) BlotStainer 全自动Blot膜杂交系统 自动原位杂交仪 查看更多试用>> 关注我们 丁香通新浪微博:丁香通 丁香通微信号:biomart
从单个小鼠肿瘤样本中分选高纯度、高活性 TIL 细胞亚群的完整工作流程
TIL 细胞分选工作流程,解决实验瓶颈:即如何将小鼠肿瘤组织高效的分离成单细胞悬液、磁珠预富集 CD45+ TIL 细胞,然后从同一样品中依次分选高纯度和高活性的 TIL 细胞亚群。 分离高纯度、高活性的 TIL 细胞亚群的工作流程 1. 肿瘤分离 利用带有加热装置的八通道全自动组织解离器 gentleMACSTM Octo 和小鼠肿瘤分离试剂盒分离 1g 小鼠肿瘤组织。 2. CD45+ TIL 的免疫磁性预富集 为了提高目标 TIL 细胞的频率及纯度,从肿瘤分离出来的单细胞悬浮液中, TIL
CRISPR-Cas9 全程实操教程:从 gRNA 设计到挑单克隆全程指导
冻存。10. 获得单克隆细胞株当肉眼可见类似于菌落的细胞团时,将其从大盘或 96 孔板消化下来转移至 12 或 24 孔板中继续扩大培养。注意不要污染到其它细胞团,不要选取过密的细胞团。11. 扩大培养,提取细胞全基因组 DNA 和细胞总蛋白12. 测序Guide 序列上游 100bp 左右和下游 200bp 左右为上下游设计一对引物,以全基因组为模板,以上述引物进行 PCR。PCR 产物送测序,或将产物用 T7E1 进行酶切消化检测突变。13. Western与阴性对照相比,靶基因应完全敲除
技术资料暂无技术资料 索取技术资料









